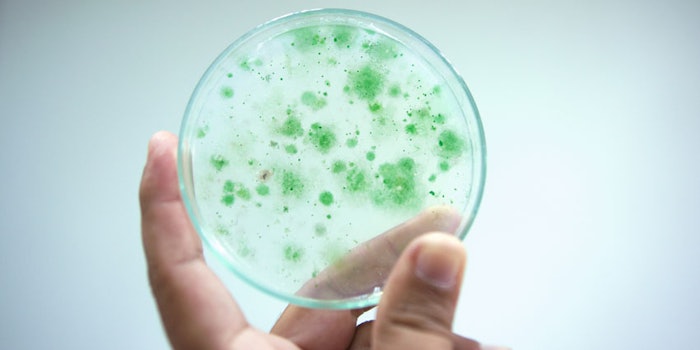

Ingredient and solutions company, Blendtek Ingredients Inc., has partnered with Spain-based Fitoplancton Marino, a company specializing in the development of marine microalgae cultures.
According to a businessinsider.com article, the partnership will supply Fitoplancton Marino's TetraSOD, an ingredient for food, health and nutrition products, and Easyalgae Plankton-Extract, a marine-based extra used for the skin and the dermoscosmetic industry.
For more information please visit www.businessinsider.com